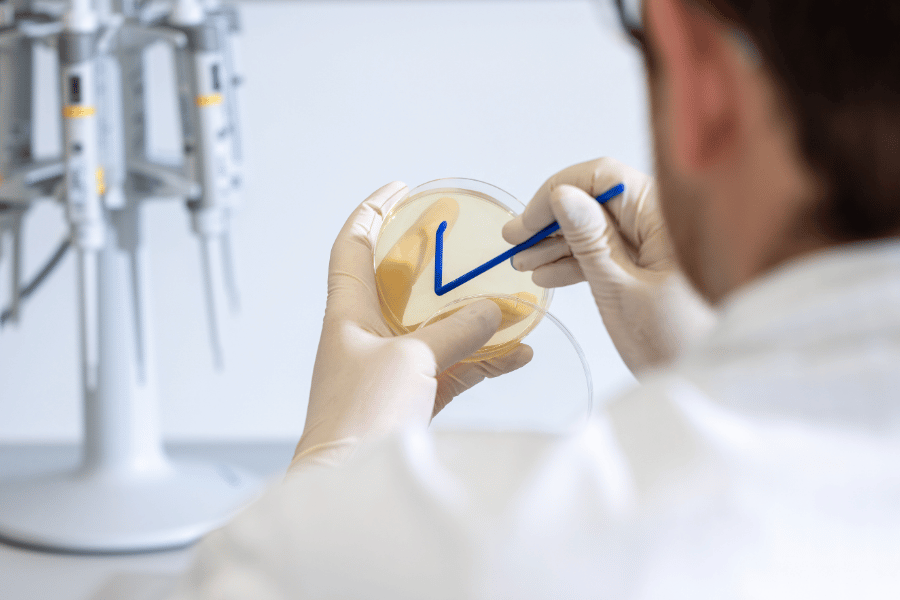
Our Expertise

Alexander Zörweg
QMAlexander is responsible for nagene’s quality management system and the establishment and maintenance of GMP-compliant structures. He leads the setup, documentation and continuous improvement of GMP-relevant processes, ensuring regulatory compliance across all DNA synthesis workflows.